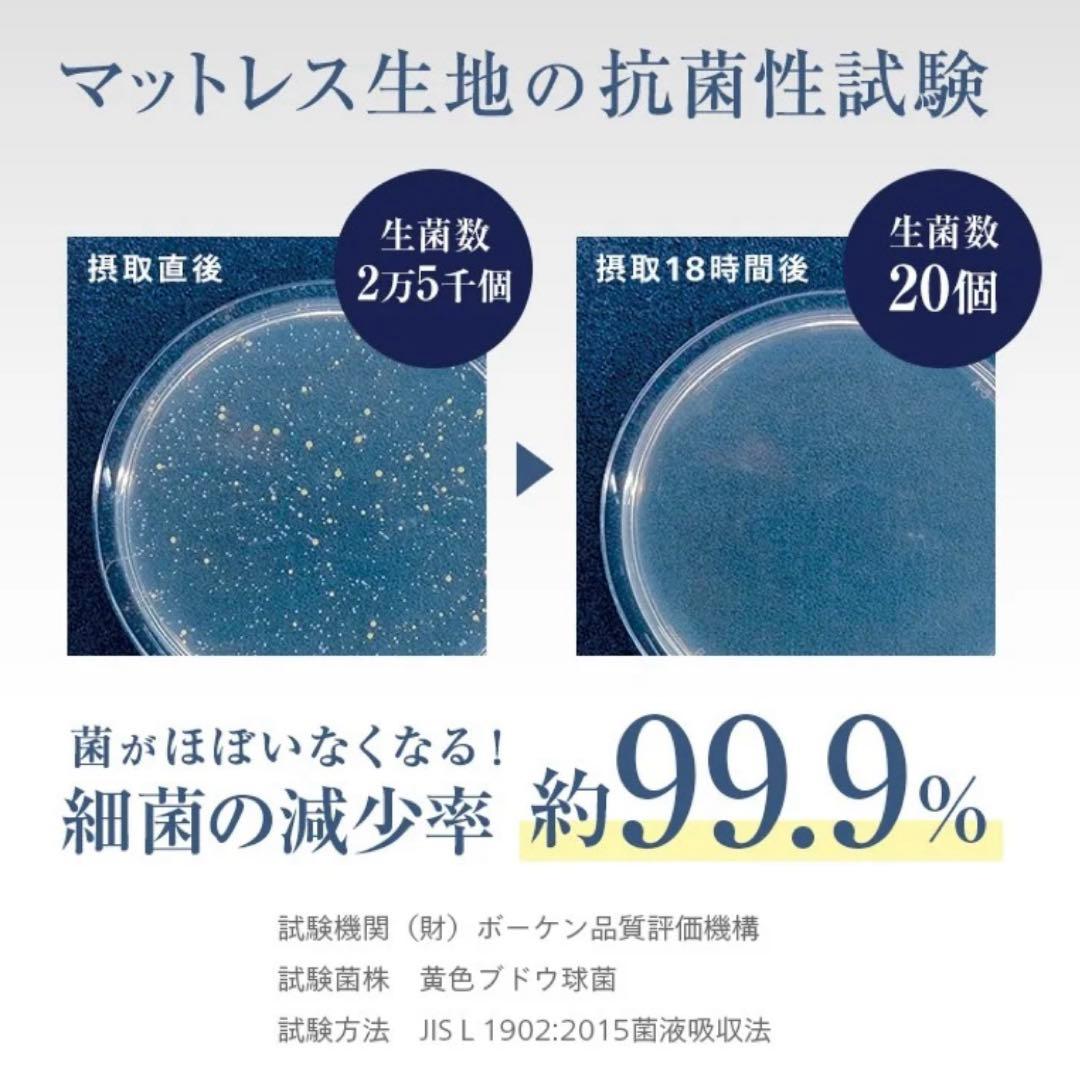
【サウルス】フランスベッド　セミダブル　マットレス　保証書付

マイストア
変更
お店で受け取る
(送料無料)
配送する
納期目安:
2026.03.09 16:52頃のお届け予定です。
決済方法が、クレジット、代金引換の場合に限ります。その他の決済方法の場合はこちらをご確認ください。
※土・日・祝日の注文の場合や在庫状況によって、商品のお届けにお時間をいただく場合がございます。
【サウルス】フランスベッド セミダブル マットレス 保証書付の詳細情報
ご覧いただきありがとうございます。人気のTWシリーズ。状態がとても良いので使っていただける方にお譲りできればと思い出品しました。【商品】フランスベッド TW-101Ag 【サイズ】セミダブル幅122cm × 高さ195cm × 厚さ24cm【素材】コイルスプリング(画像2枚目に詳細あり)【状態】目立った傷や汚れ等なくきれいな状態です。。モットン マットレス 170N レギュラー シングル。フランスベッド製のセミダブルベッドマットレス(保証書付)です。マットレス Nスリープ。エアーベッド Coleman コールマン ダブル キャップ 車中泊。硬さは、表面はソフトでやや硬めです。ユ*カ様 nishikawa 【 西川 】マットレス シングル 三つ折り 厚さ9。西川エアーマットレスA.I.R.シングルサイズエアーマットレス。※出品は2/20までとなります。フランスベッド シングルサイズ 電動マットレス RP-3000。NIHON BED ダブルスプリングマットレス&dreambed ベッドフレーム。※素人検品の為、ご理解いただける方のご購入をお願い致します。7999.テンピュール トッパーデラックス3.5 シングル
ベストセラーランキングです
近くの売り場の商品
カスタマーレビュー
オススメ度 4.9点
現在、4439件のレビューが投稿されています。

![[ERAR] [完売品] 合皮サスペンダーメタルパーツカーゴパンツ M](/qneh/nHR0cHZ6Ly9zdGF0aWZuoWVyY2RuYm5ldC9cdGVtL2EldGSpbC9vcmlnL3/Obb3Evcy9tMzQ0OTAyNjM4NzOfMS5qcGc-.jpg)
